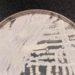
Entenda por que a Candida auris foi apelidada de superfungo

O Tribunal Federal australiano indeferiu recurso do tenista Novak Djokovic contra ordem de deportação, que implica proibição de entrar durante três anos na Austrália.

Três juízes do Tribunal Federal confirmaram decisão tomada na sexta-feira (14) pelo ministro da Imigração, de cancelar o visto do sérvio, de 34 anos, por motivos de interesse público.
A decisão significa provavelmente que Djokovic, que não está vacinado contra a covid-19, vai permanecer detido em Melbourne até ser deportado.
A ordem de deportação inclui também, geralmente, proibição de três anos de entrar no país.
Djokovic fica assim impossibilitado de disputar o Open da Austrália, que começa nesta segunda-feira (17).
O ministro cancelou o visto, alegando que a presença de Djokovic no país pode constituir risco para a saúde e “ser contraproducente para os esforços de vacinação de outros na Austrália”.
O visto de Djokovic foi inicialmente cancelado em 6 de janeiro no aeroporto de Melbourne, horas após sua chegada para competir no primeiro torneio de Grand Slam de 2022,.
Um funcionário fronteiriço cancelou o visto, depois de decidir que Djokovic não era elegível para isenção médica das regras da Austrália para visitantes não vacinados.
Fonte: Agencia Brasil